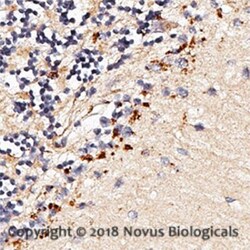
TLR7 Antibody, Novus Biologicals 0.025mg; Unlabeled:Antibodies, Polyclonal

missing translation for 'onlineSavingsMsg'
Learn More
Learn More
TLR7 Antibody, Novus Biologicals™
Rabbit Polyclonal Antibody has been used in 1 publication
Brand: Novus Biologicals NBP2-24767SS
This item is not returnable.
View return policy
Description
TLR7 Polyclonal specifically detects TLR7 in Human, Primate, Rhesus Macaque samples. It is validated for Western Blot, Flow Cytometry, Immunohistochemistry, Immunohistochemistry-Paraffin.
Specifications
| TLR7 | |
| Polyclonal | |
| Unconjugated | |
| 0.2 ml PBS and 0.05% BSA with 0.05% Sodium Azide | |
| TLR7 | |
| A portion of amino acids 900-950 of human TLR7 was used as the immunogen. | |
| 0.025 mg | |
| Cytokine Research, Immunology, Innate Immunity, Toll Like Receptors | |
| 51284 | |
| Human, Primate, Rhesus Macaque | |
| Purified |
| Western Blot, Flow Cytometry, Immunohistochemistry (Paraffin) | |
| 0.5 mg/mL | |
| Western Blot 0.5-2 ug/ml, Flow Cytometry 1-2 ug/ 10^6 cells, Immunohistochemistry, Immunohistochemistry-Paraffin reported in scientific literature (PMID 25586463) | |
| toll-like receptor 7 | |
| Rabbit | |
| Protein G purified | |
| RUO | |
| Primary | |
| The amino acid sequence used as immunogen is 100% homologous in human, chimpanzee and rhesus monkey, 83% homologous in dog and 72% homologous in mouse. | |
| Store at 4C short term. Aliquot and store at -20C long term. Avoid freeze-thaw cycles. | |
| IgG |
Product Content Correction
Your input is important to us. Please complete this form to provide feedback related to the content on this product.
Product Title
For Research Use Only
Spot an opportunity for improvement?Share a Content Correction